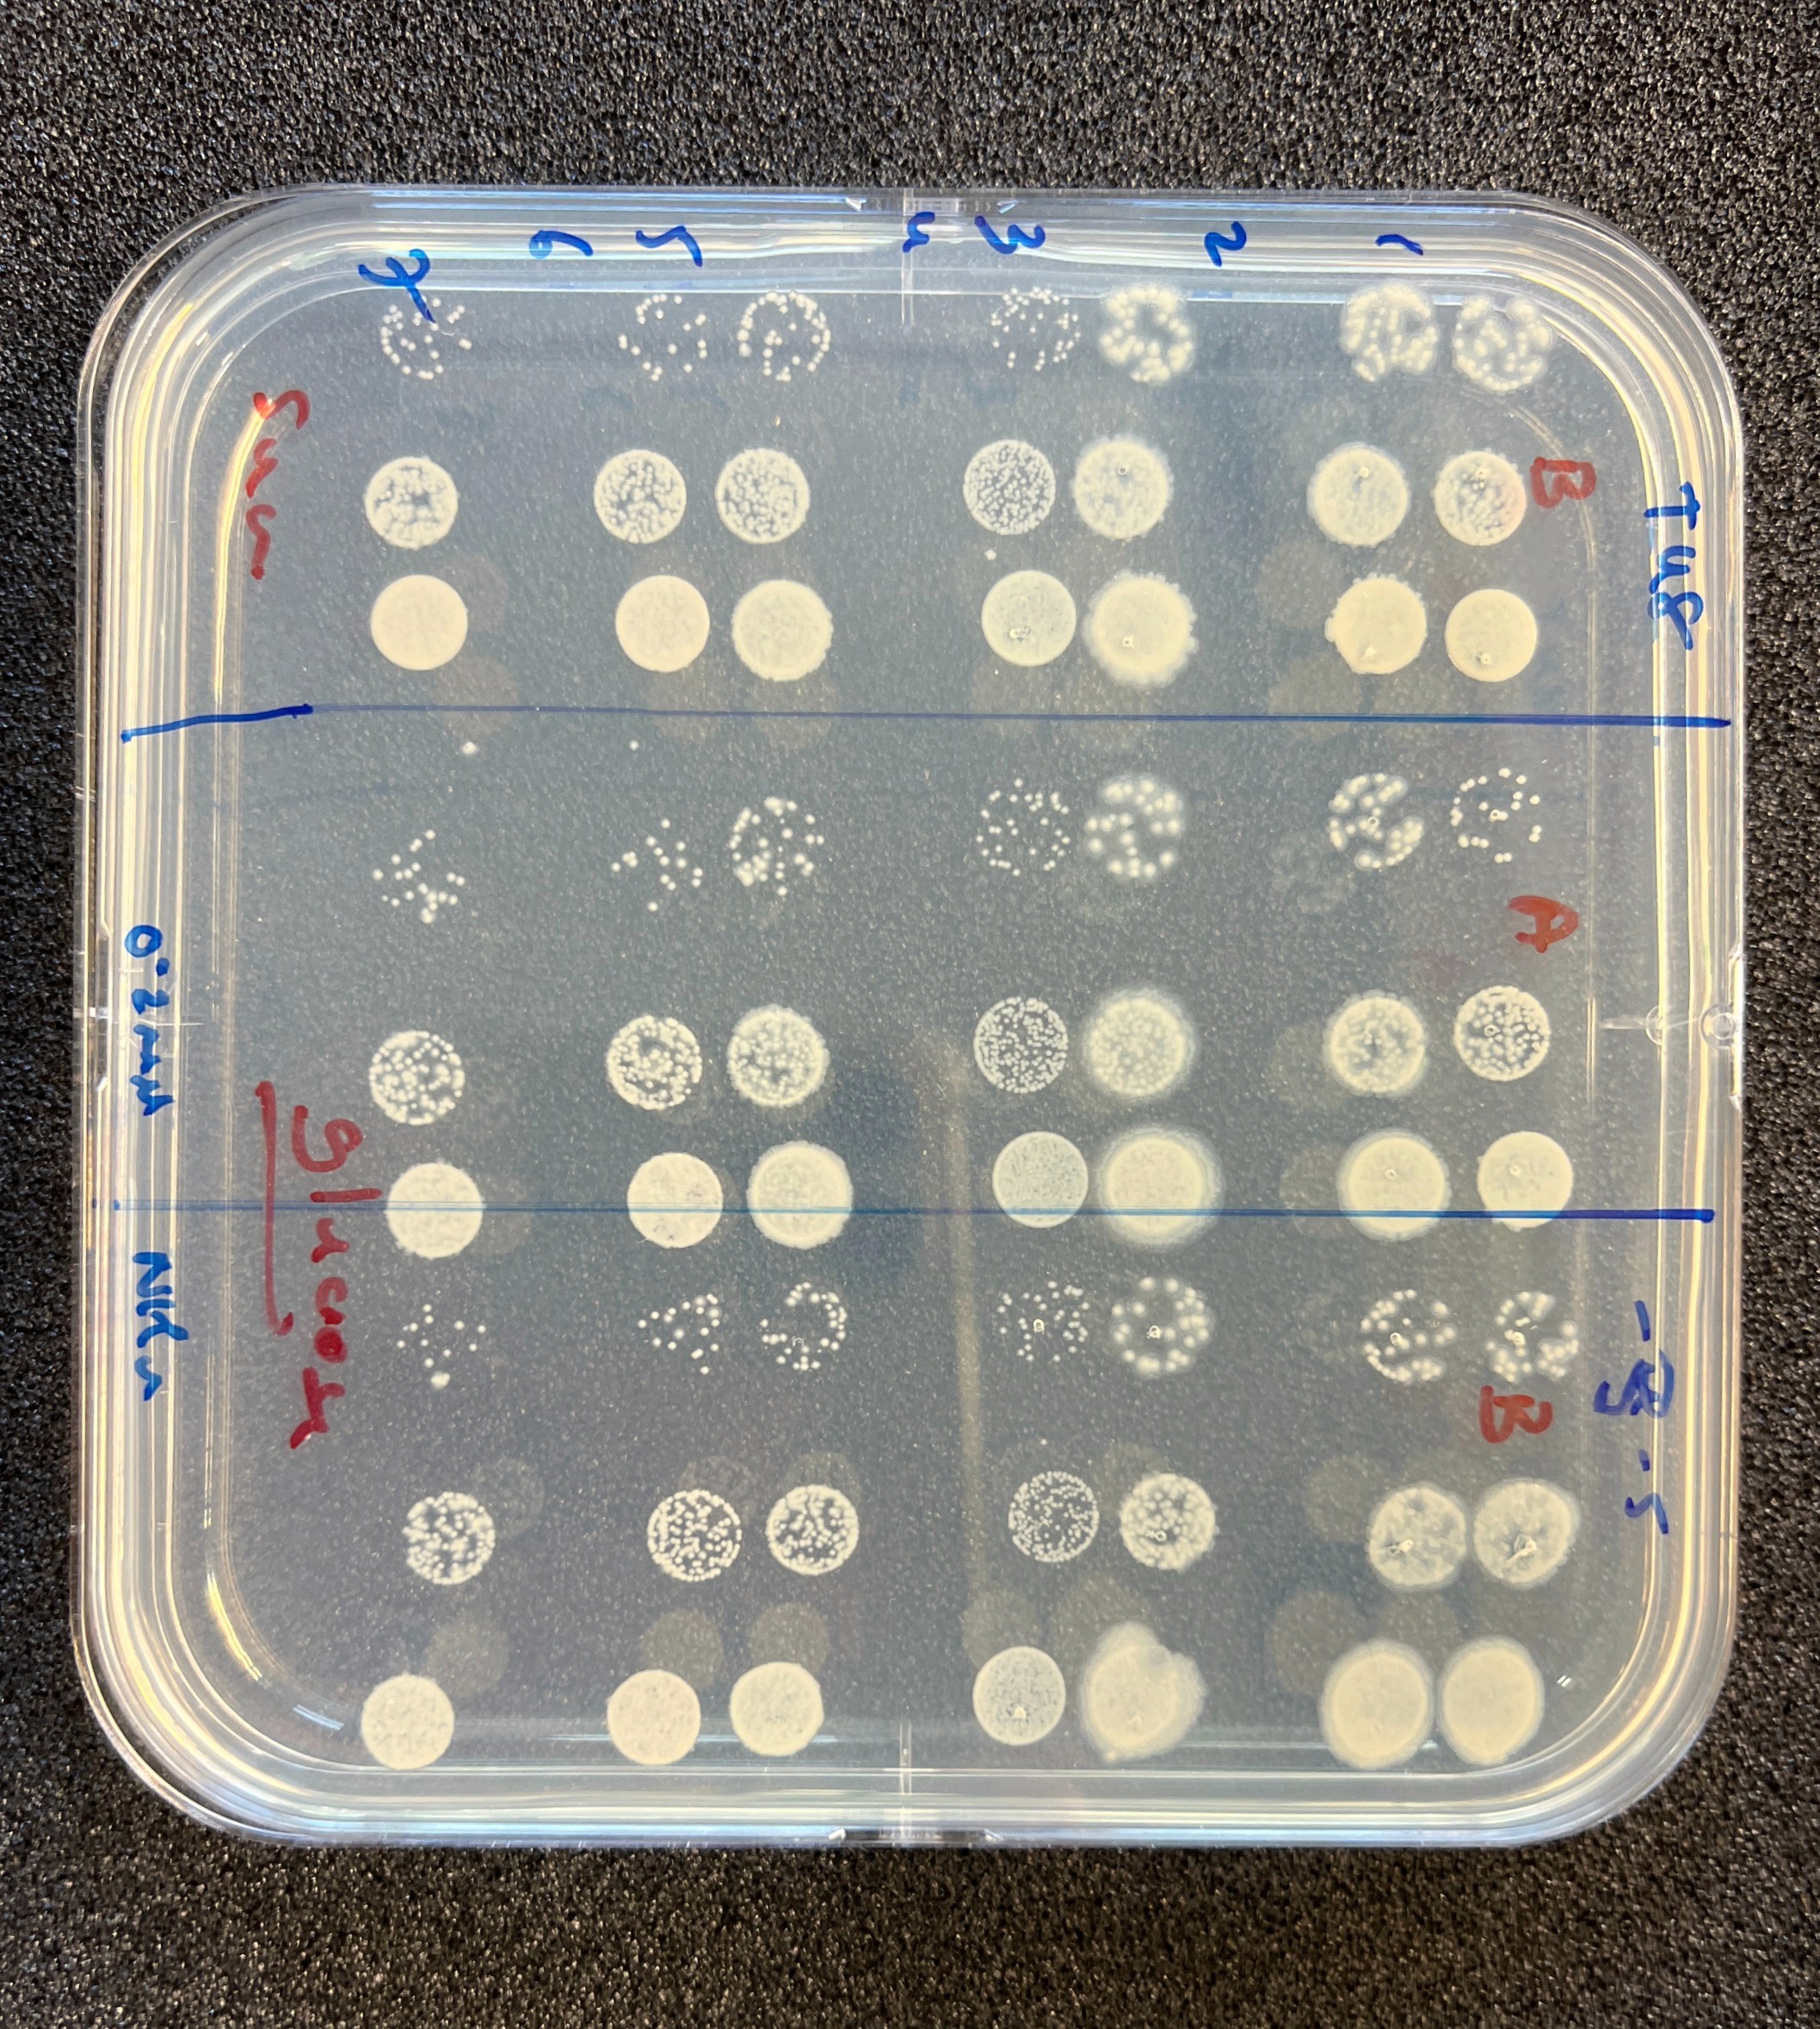

Feed the world: Announcing our investment in NetZeroNitrogen
We’re delighted to (finally) announce our investment in NetZeroNitrogen!

The NZN team: Justin, Natalie, Alan, Thomas and Gary
The development of synthetic nitrogen fertiliser in the twentieth century enabled the crop production that we need to support a global population of eight billion people - half of whom would not be here otherwise (Our World In Data). But, it’s a huge problem from a climate perspective - the manufacture and use of synthetic nitrogen fertilisers is responsible for more than 1 Gt CO2e per year. Some of this is from the production of ammonia from grey hydrogen and the Haber Bosch process, but the larger part is from field emissions of N2O after application.
NZN aims to reduce both of these issues by commercialising the use of a naturally occurring bacteria. This colonises the plant, and fixes nitrogen directly from the air - giving the plant some of the nitrogen it needs, along with a host of other potential benefits including increased solubility of other nutrients, protection from pathogens and increased drought tolerance.

Rice being grown in NZN's labs colonised by nitrogen-fixing bacteria
ZCC invested back in December 2022, and Pippa joined their Board as an Investor Director. This investment enabled the team to set up their own labs in the University of Nottingham’s Synthetic Biology research Centre, hire two research scientists and start work characterising the 35 known different strains of bacteria.
We’re now joined by our friends at Revent, who are investing alongside a cohort of angels and angel investors in a pre-seed round. Revent is an impact vc fund based in Germany, with a focus on the climate and health impacts of food systems. Revent will add a Board Observer, and Pippa will remain the Investor Director.
NZN have an exciting year ahead of them with several key hires including a CTO to lead field trials, and development of their commercial strategy.
“The manufacture and use of synthetic fertiliser contributes around a billion tons of CO2e to the atmosphere every year - as well as causing issues with soil health and excess nutrients in waterways. We’re very excited about the potential of NZN’s bacteria-based alternative to reduce this damage, giving crops nutrients more efficiently and effectively, and working in harmony with nature. Justin, Gary and Alan have the right combination of deep scientific expertise and business leadership to deliver on the promise of this tiny organism to revolutionise the world’s agriculture.”